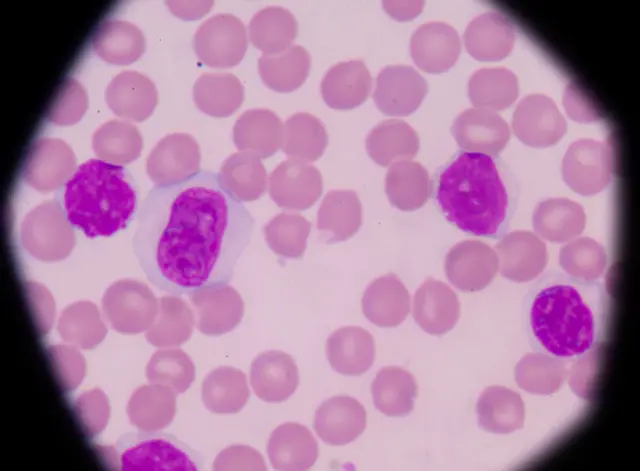
células T

Qué es y cómo funciona la inmunoterapia, el tratamiento que Jimmy Carter dice le curó el cáncer

Fuente de la imagen, Getty
- Autor, Lucía Blasco
- Título del autor, BBC Mundo
El expresidente de Estados Unidos, Jimmy Carter, dio por concluida su batalla contra el cáncer y aseguró que, según sus médicos, ya no necesitará continuar con el tratamiento.
Carter, de 91 años, reveló que sufría cáncer en agosto de 2015: un melanoma que se le había propagado al cerebro.
Y los oncólogos decidieron tratarlo con radiaciones focalizadas en los tumores y un medicamento para reforzar su sistema inmunológico.
El exmandatario estuvo seis meses recibiendo el tratamiento, conocido como inmunoterapia.
Y luego de anunciar, en diciembre pasado, que estaba libre de cáncer, este fin de semana dio más buenas noticias.
- <bold><link type="page"><caption> EE.UU.: Jimmy Carter anuncia que está libre de cáncer</caption><url href="http://www.bbc.com/mundo/noticias/2015/12/151206_eeuu_jimmy_carter_sin_cancer_bd.shtml" platform="highweb"/></link></bold>
"(La semana pasada) me hicieron una resonancia magnética durante dos horas y diez minutos, y los doctores determinaron que no necesitaba más tratamiento", informó el exmandatario durante unas clases de catequesis que imparte semanalmente en una iglesia bautista de su ciudad natal: Plains, Georgia.
Pero, ¿cuál fue el tratamiento seguido por Carter? y ¿qué riesgos implica?
Inmunoterapia
"Se llama inmunoterapia y, básicamente, eliminó los obstáculos para que mi propio sistema inmunitario pueda luchar contra el cáncer", explicó el mandatario.
"Es algo complicado, pero ha funcionado muy bien para mí", aseguró.

Fuente de la imagen, AP
Y la interrupción del tratamiento fue confirmada por la portavoz del Centro Carter, Deanna Congileo, quien le explicó a ABC News que el expresidente norteamericano "continuará haciéndose chequeos y lo reanudará si fuera necesario".
- <bold><link type="page"><caption> ¿Qué es el melanoma cerebral que padece Jimmy Carter y cómo se extiende?</caption><url href="http://www.bbc.com/mundo/noticias/2015/08/150820_eeuu_jimmy_carter_cancer_ep" platform="highweb"/></link></bold>
El tratamiento del exmandatario todavía puede calificarse como experimental y está basado en un medicamento llamado pembrolizumab, que se comercializa bajo el nombre de Keytruda.
Su uso para pacientes con melanoma fue aprobado por la Administración de Alimentos y Medicamentos de Estados Unidos (FDA) en septiembre de 2014, aunque ya se utilizaba desde 2011 para otros tipos de cáncer.
Tal y como explicó la FDA cuando aprobó su uso en 2014, "es una técnica revolucionaria porque las pruebas clínicas preliminares mostraron que el fármaco puede ofrecer una mejora sustancial en comparación con las terapias disponibles".

Fuente de la imagen, Getty
"Lo que estas medicinas hacen es que el sistema inmunológico pueda ver la presencia del tumor y reaccionar contra éste", explicó a BBC Mundo Jose Lutzky, oncólogo del Mount Sinai Medical Center en Miami (EE.UU.), cuando Carter reveló su enfermedad.
Y, en ese momento (agosto de 2015), el especialista ya calificaba a la nueva terapia como "un avance muy importante" y aseguraba que estaba dando "buenos y duraderos resultados".
- <link type="page"><caption> El descubrimiento del "talón de Aquiles" del cáncer que podría abrir la puerta a nuevos tratamientos</caption><url href="http://www.bbc.com/mundo/noticias/2016/03/160304_cancer_tratamiento_sistema_inmunologico_cancer_research_mr.shtml" platform="highweb"/></link>
Combatiendo las células T
Las posibilidades de la inmunoterapia, sin embargo, deben ser puestas en perspectiva.
Según el centro británico dedicado a la investigación del cáncer, Cancer Research UK, se trata de un tratamiento para aquellos melanomas "que ya se propagaron y que no pueden eliminarse con cirugía".
Aunque según fuentes de la fundación, "también se utiliza como parte de ensayos clínicos para tratar otros tipos de cáncer".
Según los oncólogos del centro británico, "este tipo de tratamiento estimula el sistema inmunológico para combatir las células cancerosas".
Martin Ledwick, enfermero jefe de comunicación de Cancer Research UK, le contó a BBC Mundo que "el pembrolizumad es unas de las nuevas terapias biológicas disponibles en el sistema de salud inglés (NHS) para tratar el melanoma avanzado".
"Este tipo de terapias biológicas son muy prometedoras y, aunque puede que no sean beneficiosas para todos los pacientes, están proporcionando uno de los desarrollos más prometedores para el tratamiento del melanoma en muchos años".
Concretamente, permite localizar y bloquear una proteína llamada PD-1 que se encuentran en las células del sistema inmunológico, llamadas linfocitos T o células T.
Fuente de la imagen, thinkstock
De hecho, cada vez son más las terapias experimentales para combatir este tipo de células a través del sistema inmunológico. Y los resultados parecen estar siendo muy satisfactorios.
- <bold><link type="page"><caption> Lo que se sabe de la prometedora terapia contra el cáncer que logró remisión en hasta un 94% de casos</caption><url href="http://www.bbc.com/mundo/noticias/2016/02/160216_cancer_terapia_linfocito_am" platform="highweb"/></link></bold>
Además, en el caso del fármaco que posibilitó la cura de Carter, los expertos aseguran que se trata de una medicación menos tóxica que la quimioterapia.
"Estas medicinas tienen un espectro de efectos secundarios muy tolerables", dijo Lutzky.
Aunque, según los especialistas, también puede tener algunas contrapartidas.
Efectos secundarios
Efectivamente, ciertas investigaciones mostraron que el pembrolizumab, que se administra en forma de inyección intravenosa, puede causar reacciones en el colon, el hígado o los pulmones.
Además, algunos de los efectos secundarios –experimentados en más del 10% de los pacientes, según Cancer Research UK– son la fatiga y el cansancio, reacciones en la piel, diarrea, naúseas y dolor en las articulaciones.

Fuente de la imagen, thinlstock
Otros efectos –que experimentan menos del 10% de los pacientes– son pérdida de apetito, mareos, dolor en el pecho y pérdida del cabello.
Y los médicos desaconsejan el uso de este fármaco para mujeres embarazadas.
Además, todavía están tratando de determinar por cuánto tiempo puede el tratamiento lograr que nuestro sistema inmunológico continúe luchando.
Según explicó a BBC Mundo Marco Gerlinger, oncólogo del Institute of Cancer Research de Londres, "el éxito de la inmunoterapia se produce de forma bastante inesperada, tras décadas de investigación".
"Este tipo de terapias son excpecionalmente exitosas en algunos pacientes e incluso pueden haberlos curado", dijo el experto.
"Funcionan especialmente bien en algunos tipos de cáncer que se consideran muy resistentes a otros tratamientos, como es el caso del melanoma de Jimmy Carter",
Enfoque personalizado
Gerlinger asegura, no obstante, que "el dilema al que nos enfrentamos ahora es que muchos tipos de tumor no se benefician de la inmunoterapia".
"Estamos invirtiendo un gran esfuerzo en investigación para comprender por qué algunos tipos de cáncer responden (a la inmunoterapia) y por que otros son resistentes, y si podemos reeducar al sistema inmunológico para atacar a estos últimos".
Según el oncólogo, algunos de los estudios que se están haciendo incluyen el desarrollo de vacunas personalizadas o de medicamentos para activar el sistema inmunológico y lograr que éste ataque las células del cáncer.
"Estamos comenzando a comprender que la interacción entre el sistema inmunológico y las células cancerosas es bastante compleja".
Y advirtió: "Es poco probable que el mismo método de inmunoterapia funcione para todos los pacientes, y podríamos necesitar un enfoque mucho más personalizado".
Y Charlotte Libov, experta en tratamientos contra el cáncer y autora del libro Cancer Survival Guide ("Guía para sobrevivir al cáncer"), asegura que, a pesar del "inusual éxito" del tratamiento en el expresidente Carter, "es demasiado temprano para determinar si este tipo de tratamientos, la inmunoterapia, funciona realmente, porque es muy nuevo".
Aunque reconoce que "la buena noticia es que el anuncio de Carter ofrece esperanza a los enfermos de cáncer, especialmente teniendo en cuenta la edad del expresidente".









